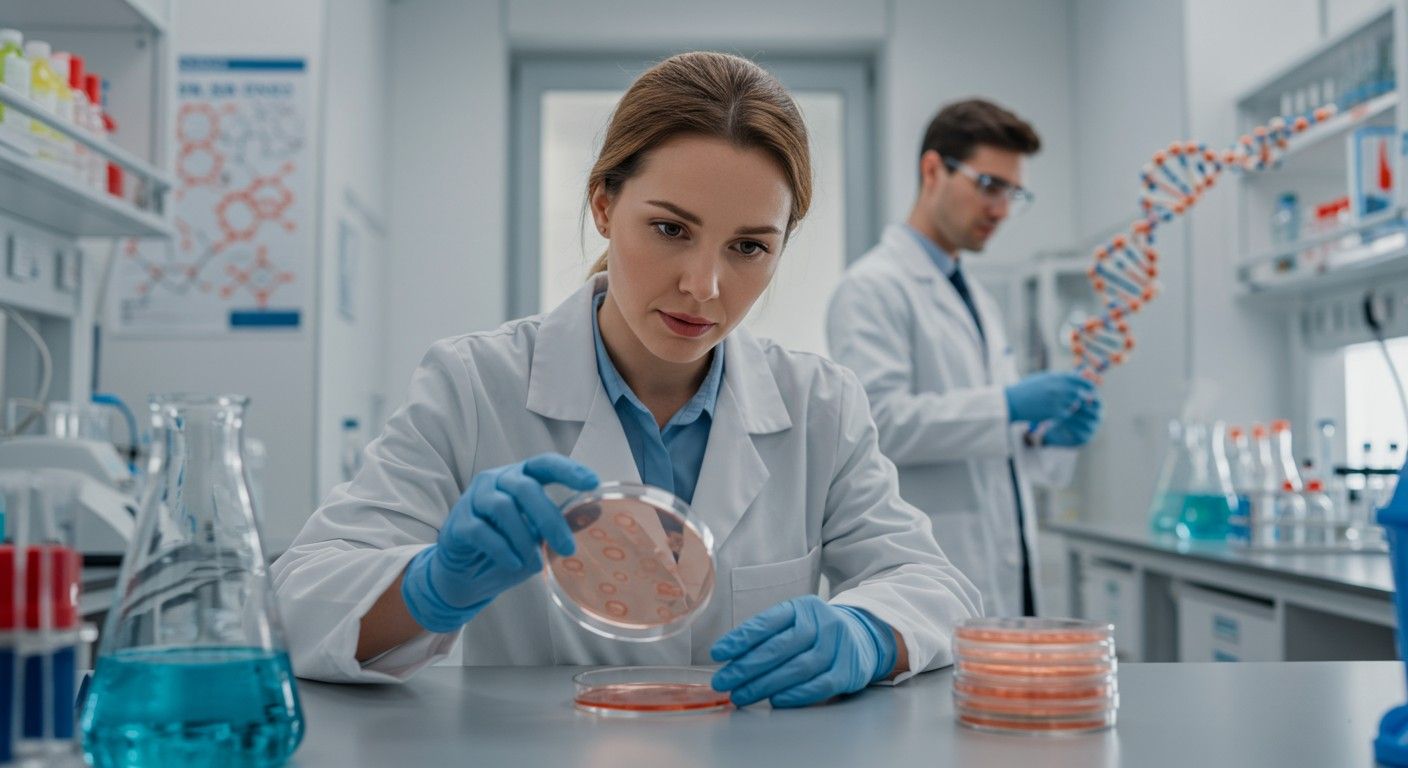
A DNázok célzottan segíthetnek a daganatos sejtek elpusztításában.

A biológiai rendszerek komplex hálózatában a dezoxiribonukleinsav (DNS) a genetikai információ elsődleges hordozója, amely minden élőlény működéséhez és öröklődéséhez elengedhetetlen. Ennek a létfontosságú molekulának az integritását szigorúan őrzik a sejtek, ám bizonyos folyamatok során – legyen szó normális élettani funkciókról, mint a DNS javítás, vagy kóros állapotokról, mint a sejtpusztulás – szükség van a DNS lebontására, átalakítására vagy fragmentálására. Ezt a kritikus feladatot végzik el a dezoxiribonukleázok, rövidebb nevén DNázok, amelyek a nukleázok családjába tartozó enzimek. Működésük alapvető a genom stabilitásának fenntartásában, a sejtciklus szabályozásában, az immunválaszban és számos molekuláris biológiai alkalmazásban. Ezek az enzimek hidrolizálják a DNS foszfodiészter kötéseit, ezzel kisebb fragmensekre bontva a nukleinsav láncát.
A DNázok felfedezése és kutatása hosszú múltra tekint vissza, és az elmúlt évtizedekben jelentősen hozzájárult a molekuláris biológia és a genetika fejlődéséhez. Először a hasnyálmirigyben izoláltak ilyen enzimet, a ma már klasszikusnak számító DNáz I-et, amely azóta is az egyik legszélesebben vizsgált és alkalmazott dezoxiribonukleáz. Azonban a DNázok családja sokkal sokrétűbb, mint azt elsőre gondolnánk, és magába foglal számos, eltérő specifikussággal, optimális pH-val és ionigénnyel rendelkező enzimet, amelyek mind sajátos biológiai szerepet töltenek be. A genetikai információ tárolásának és felhasználásának precíz szabályozása elképzelhetetlen lenne ezen enzimek nélkül, hiszen ők felelősek a DNS dinamikus kezeléséért, legyen szó akár a hibás szakaszok eltávolításáról, akár a sejt programozott megsemmisítéséről.
A DNázok tanulmányozása nem csupán elméleti érdeklődésre tarthat számot. Mélyreható megértésük kulcsfontosságú a számos betegség patomechanizmusának feltárásában, valamint új diagnosztikai és terápiás stratégiák kidolgozásában. A cisztás fibrózis kezelésétől az autoimmun betegségek kutatásáig, a DNázok a modern orvostudomány és biotechnológia alapvető eszközeivé váltak, amelyek egyre inkább a figyelem középpontjába kerülnek a személyre szabott medicina korában.
A dezoxiribonukleázok alapvető működése és osztályozása
A dezoxiribonukleázok olyan enzimek, amelyek a dezoxiribonukleinsav (DNS) molekuláinak foszfodiészter kötéseit hidrolitikusan hasítják. Ez a folyamat a DNS-lánc kisebb egységekre, oligonukleotidokra vagy mononukleotidokra való fragmentálódásához vezet. Működésük alapvető fontosságú a sejtek számára, hiszen lehetővé teszi a hibás vagy felesleges DNS eltávolítását, a genetikai anyag újrarendeződését és a programozott sejthalál során a DNS kontrollált lebontását. Az enzimatikus reakció során a vízmolekula betör a foszfodiészter kötésbe, felhasítva azt, és így egy szabad hidroxil- és egy foszfátcsoportot hoz létre a DNS-gerincen.
Az enzimatikus aktivitásukat tekintve a DNázokat két fő kategóriába sorolhatjuk: exonukleázokra és endonukleázokra. Ez a megkülönböztetés azon alapul, hogy az enzim hol kezdi meg a DNS-lánc hasítását és milyen irányban halad.
- Exonukleázok: Ezek az enzimek a DNS-lánc végeiről, azaz a 3′ vagy az 5′ vég felől távolítanak el nukleotidokat. Működésük irányított, és fokozatosan rövidítik a DNS-molekulát. Példaként említhetőek a DNS-polimerázok 3’→5′ exonukleáz aktivitásai, amelyek a másolási hibák kijavításában játszanak szerepet, biztosítva a replikáció pontosságát. Emellett léteznek 5’→3′ exonukleázok is, amelyek a primerek eltávolításában vesznek részt.
- Endonukleázok: Ezzel szemben az endonukleázok a DNS-lánc belső részén, tehát a lánc közepén hasítják a foszfodiészter kötéseket. Ez a csoport rendkívül sokszínű, ide tartoznak a restrikciós enzimek is, amelyek specifikus felismerési szekvenciákkal rendelkeznek, valamint a nem specifikus endonukleázok, amelyek bárhol képesek hasítani. Az endonukleázok képesek egyetlen szálat (nick) vagy mindkét szálat (double-strand break) hasítani, ami alapvető különbséget jelent a biológiai következmények szempontjából.
Ezen túlmenően a DNázokat további kritériumok alapján is osztályozhatjuk, például a pH optimumuk, az ionigényük (pl. magnézium, kalcium, cink), a szubsztrát specifikusságuk (egy- vagy kétszálú DNS, DNS-RNS hibridek) vagy a hasítási termékeik (pl. 3′-OH és 5′-P, vagy 3′-P és 5′-OH végződések) alapján. Ezen tulajdonságok határozzák meg az enzim biológiai szerepét és a molekuláris biológiai alkalmazhatóságát. Az egyes DNázok egyedi jellemzői teszik lehetővé a sejtek számára, hogy precízen szabályozzák a DNS-metabolizmus különböző aspektusait, alkalmazkodva a változó környezeti feltételekhez és belső szükségletekhez.
A DNázok főbb típusai és jellemzőik
A DNázok családja rendkívül sokszínű, számos különböző enzimet foglal magába, amelyek eltérő biokémiai tulajdonságokkal és biológiai funkciókkal rendelkeznek. Néhány kulcsfontosságú típus részletesebb bemutatása segít megérteni ezen enzimek komplexitását és jelentőségét, valamint a biológiai rendszerekben betöltött specifikus szerepüket.
DNáz I: a prototípus enzim
A DNáz I (dezoxiribonukleáz I) a legismertebb és leginkább tanulmányozott DNáz. Ez az enzim főként a hasnyálmirigyben termelődik, de megtalálható más szövetekben is, mint például a vesében, a lépben, a bélben és a vérplazmában. A DNáz I egy endonukleáz, amely a kettős szálú DNS-t véletlenszerűen hasítja, jellemzően 3′-hidroxil és 5′-foszfát csoportokat eredményezve a hasítási pontokon. Ez a specifikus végződés fontos a downstream enzimek, például a ligázok számára.
Működéséhez kétértékű kationokra, mint például Mg2+-ra vagy Ca2+-ra van szüksége. A magnéziumionok jelenlétében a DNáz I egyenlő arányban hoz létre tompa és ragadós végeket, míg kalciumionok jelenlétében, magnézium hiányában, elsősorban egyetlen szálon hasít, ezzel úgynevezett „nicks”-eket (egyszálú töréseket) hozva létre. Ez a kettős kationfüggőség kulcsfontosságú a működésének szabályozásában és az alkalmazási területek diverzitásában, lehetővé téve a kutatók számára, hogy a reakció körülményeinek finomhangolásával irányítsák az enzim aktivitását és hasítási mintázatát.
A DNáz I optimális pH-ja enyhén lúgos tartományba esik, általában 7,0-8,0 között. Molekuláris tömege körülbelül 31 kDa, és több izoformája is létezik, amelyek kissé eltérő tulajdonságokkal rendelkezhetnek. Ez az enzim a pankreatikus szekréció fontos komponense, ahol szerepet játszhat a táplálékkal bevitt nukleinsavak lebontásában. A keringő DNáz I a vérplazmában is aktív, ahol a szabadon lebegő DNS eltávolításáért felel, hozzájárulva a genom stabilitásának fenntartásához és az immunválasz modulálásához.
„A DNáz I nem csupán egy enzim, hanem a molekuláris biológia egyik alappillére, amelynek sokoldalúsága számtalan kutatási és terápiás alkalmazáshoz vezetett, a laboratóriumtól a klinikai gyakorlatig.”
DNáz II: a lizoszómális DNáz
A DNáz II egy másik jelentős dezoxiribonukleáz, amely leginkább a lizoszómákban található meg. Ebből adódóan optimális pH-ja savas tartományba esik, jellemzően 4,5-5,5 között. Ellentétben a DNáz I-gyel, a DNáz II nem igényel kétértékű kationokat a működéséhez, bár bizonyos fémionok, mint a Fe2+, stimulálhatják aktivitását. Ez az enzim a 3′-foszfát és 5′-hidroxil csoportokat eredményez a hasítási pontokon, ami eltér a DNáz I által generált végződésektől.
A DNáz II endonukleázként működik, és a kettős szálú DNS-t hasítja. Fő szerepe a sejten belüli DNS-lebontásban van, különösen az apoptózis (programozott sejthalál) során, ahol a sejtmagban fragmentálja a DNS-t, valamint a fagocitózis során, amikor a bekebelezett sejtek DNS-ét emészti. A lizoszómákban a DNáz II a bekebelezett sejtek, baktériumok vagy vírusok genetikai anyagának végleges lebontásáért felel, megakadályozva a nem kívánt genetikai anyag felhalmozódását a sejtben. Ezenkívül a DNáz II részt vesz a sejtmag DNS-ének lebontásában a vörösvértestek érése során is, ahol a sejtmag kiürítése alapvető a funkcionális eritrociták kialakulásához.
Mikrokokkális nukleáz (MNáz): a kromatin szerkezet vizsgálója
A mikrokokkális nukleáz (MNáz) egy endonukleáz, amelyet a Staphylococcus aureus baktériumból izoláltak. Ez az enzim kivételes tulajdonsággal rendelkezik: képes hasítani mind az egy-, mind a kétszálú DNS-t, sőt, az RNS-t is, bár a DNS-re mutat nagyobb affinitást. Működéséhez Ca2+ ionokra van szüksége, és optimális pH-ja enyhén lúgos tartományba esik, jellemzően 7,0-9,0 között.
Az MNáz különösen fontos eszközzé vált a kromatin szerkezetének tanulmányozásában. Mivel preferenciálisan hasítja azokat a DNS-régiókat, amelyek nincsenek szorosan kötve hisztonfehérjékhez (azaz a linkerer DNS-t), lehetővé teszi a nukleoszómák, a kromatin alapvető egységeinek izolálását és vizsgálatát. Az MNáz-emésztés mértékének szabályozásával a kutatók feltérképezhetik a nukleoszómák elhelyezkedését a genomon belül, ami kulcsfontosságú a génexpresszió szabályozásának megértésében. Az MNáz-seq (MNase-sequencing) technika forradalmasította a nukleoszóma pozicionálásának és a kromatin nyitottságának vizsgálatát, betekintést nyújtva a génszabályozás epigenetikai mechanizmusaiba.
Egyéb említésre méltó DNázok
A fentieken kívül számos más DNáz is létezik, amelyek specifikus funkciókkal rendelkeznek, és hozzájárulnak a DNS-metabolizmus komplexitásához.
- Serratia marcescens nukleáz (SMNáz): Egy nem-specifikus endonukleáz, amelyet a Serratia marcescens baktérium termel. Ez az enzim képes hasítani mind DNS-t, mind RNS-t, és magas aktivitása miatt széles körben alkalmazzák a molekuláris biológiai laboratóriumokban a nukleinsavak eltávolítására. Különösen hasznos a viszkózus sejtlizátumok kezelésére, mivel hatékonyan csökkenti a nukleinsavak okozta viszkozitást.
- Endonukleáz G (EndoG): Egy mitokondriális nukleáz, amely normális körülmények között a mitokondriumok belső membránja és a mátrix között található. Az apoptózis során a citoplazmába kerül, majd a sejtmagba transzlokálódik, ahol hozzájárul a DNS fragmentációjához, különösen a kettős szálú törések kialakításával. Működéséhez magnéziumionokra van szüksége.
- Restrikciós endonukleázok: Bár gyakran külön kategóriába sorolják őket, lényegében specifikus DNázok, amelyek meghatározott nukleotid szekvenciákat (palindromokat) ismernek fel és hasítanak. Ezek a molekuláris ollók forradalmasították a genetikai manipulációt, lehetővé téve a DNS klónozását, vágását és újraegyesítését, ami a rekombináns DNS technológia alapját képezi.
- Bakteriális exonukleázok: Számos baktérium termel exonukleázokat, amelyek részt vesznek a DNS-javításban, a rekombinációban vagy akár virulencia faktorként is működhetnek. Például az E. coli Exonukleáz III és Exonukleáz VII fontos szerepet játszik a DNS-javításban, eltávolítva a hibás vagy károsodott nukleotidokat a DNS-lánc végeiről.
- Mammális exonukleázok: Az emberi sejtekben is számos exonukleáz található, mint például az Exonukleáz I (TREX1), amely a citoplazmában lévő szabad DNS lebontásáért felelős. Ennek az enzimnek a mutációi autoimmun betegségekhez vezethetnek, mivel a felhalmozódó DNS immunválaszt válthat ki.
A DNázok biológiai szerepe: a genom őrétől a sejthalál irányítójáig
A dezoxiribonukleázok nem csupán egyszerű DNS-hasító enzimek; kulcsszerepet játszanak számos alapvető biológiai folyamatban, amelyek elengedhetetlenek az élet fenntartásához, a betegségekkel szembeni védekezéshez és a genetikai anyag integritásának megőrzéséhez. Ezek az enzimek a sejt élete során folyamatosan részt vesznek a DNS dinamikus kezelésében, a legapróbb hibák kijavításától a teljes genetikai állomány szisztematikus lebontásáig.
DNS-javítás és genom integritás
A DNS folyamatosan ki van téve károsító hatásoknak, mind endogén (pl. anyagcsere melléktermékek, replikációs hibák), mind exogén (pl. UV-sugárzás, ionizáló sugárzás, vegyi anyagok) forrásokból. Az ilyen károsodások, ha nem javítják ki őket, mutációkhoz, kromoszóma-átrendeződésekhez és akár rákos megbetegedésekhez vezethetnek. A DNS-javító mechanizmusok bonyolult hálózatában a DNázok létfontosságú szerepet töltenek be.
Például a nukleotid excíziós javítás (NER) során a károsodott nukleotidokat tartalmazó DNS-szakaszt egy endonukleáz hasítja ki a sérült régió mindkét oldalán. Ezt követően egy exonukleáz segíthet a fragmentált szakasz eltávolításában, majd a DNS-polimeráz szintetizálja az új szakaszt, és a ligáz összeköti a végeket. Hasonlóképpen, a bázis excíziós javítás (BER) során a glikozilázok eltávolítják a hibás bázist, majd az AP-endonukleáz hasítja a foszfodiészter gerincet, utat nyitva a javításnak. Az exonukleázok, mint például a DNS-polimerázok proofreading aktivitásai, azonnal korrigálják a replikáció során elkövetett hibákat, ezzel minimalizálva a mutációk esélyét.
A szabadon lebegő vagy hibás DNS-fragmensek felhalmozódása káros lehet a sejtre, mivel immunválaszt válthat ki vagy akadályozhatja a normális celluláris folyamatokat. A DNázok biztosítják ezen nem kívánt DNS-maradványok hatékony lebontását, ezzel fenntartva a genom integritását és a sejt belső egyensúlyát. Ez a folyamatos „takarítás” elengedhetetlen a sejt normális működéséhez és a genetikai stabilitáshoz.
Apoptózis és programozott sejthalál
Az apoptózis, vagy programozott sejthalál, egy szigorúan szabályozott folyamat, amely elengedhetetlen a fejlődéshez, a szövetek homeosztázisának fenntartásához és a potenciálisan káros sejtek (pl. vírusfertőzött, tumoros sejtek) eltávolításához. Az apoptózis egyik legjellemzőbb morfológiai jele a DNS fragmentációja, azaz a genetikai anyag rendezett, nukleoszóma méretű darabokra való feldarabolódása, ami a jellegzetes „DNS létra” mintázatot eredményezi gélelektroforézisen.
Ebben a folyamatban számos DNáz vesz részt. A legfontosabb az aktivált kaszpáz által mediált dezoxiribonukleáz (CAD), amelyet normális körülmények között egy inhibitor, az ICAD (inhibitor of CAD) inaktivál. Apoptotikus stimulus hatására a kaszpáz-3 aktiválódik, és hasítja az ICAD-t, felszabadítva a CAD-t. A szabad CAD ezután a sejtmagba transzlokálódik, és elkezdi a DNS-t nukleoszóma közötti régiókban hasítani, létrehozva a jellegzetes 180-200 bázispár hosszúságú DNS-fragmenseket, amelyek a nukleoszómáknak felelnek meg.
A DNáz II is hozzájárul az apoptotikus DNS fragmentációhoz, különösen a későbbi fázisokban, amikor a lizoszómákból felszabadulva savas környezetben működik, tovább bontva a CAD által már fragmentált DNS-t. Ezenkívül az Endonukleáz G, amely normális körülmények között a mitokondriumokban található, apoptotikus jelek hatására a citoplazmába, majd a sejtmagba kerül, és szintén részt vesz a DNS lebontásában. Ezek az enzimek összehangolt működése biztosítja a genetikai anyag szabályozott eltávolítását a haldokló sejtekből, elkerülve a gyulladásos válasz kiváltását, ami a nekrotikus sejthalálra jellemző. A DNS fragmentációja kulcsfontosságú az apoptotikus testek kialakulásához, amelyeket aztán a fagociták hatékonyan eltávolítanak.
Immunválasz és neutrofil extracelluláris csapdák (NETs)
Az immunrendszer lenyűgöző stratégiákat alkalmaz a kórokozók elleni védekezésben. Az egyik ilyen mechanizmus a neutrofil extracelluláris csapdák (NETs) képződése, amelyet a neutrofilek, a leggyakoribb fehérvérsejtek hoznak létre. A NETs hálózatos szerkezetek, amelyek a sejtmagból származó DNS-ből, hisztonokból és granuláris fehérjékből állnak. Ezek a csapdák képesek megkötni és inaktiválni a baktériumokat, gombákat és vírusokat, megakadályozva azok terjedését. A NETs képződés egy programozott sejthalál forma, a NETózis, amely során a neutrofil sejt feláldozza magát a kórokozók elleni védekezés érdekében.
Azonban a NETs felszabadulása kétélű fegyver lehet. Bár létfontosságú a fertőzések elleni védekezésben, a túlzott vagy nem kontrollált NET-képződés hozzájárulhat autoimmun betegségek (pl. szisztémás lupus erythematosus), trombózis és szepszis kialakulásához. Itt lépnek színre a DNázok. A plazma DNáz I, más néven szérum DNáz, kulcsszerepet játszik a NETs lebontásában a véráramban. Ez az enzim lebontja a szabadon lebegő DNS-hálózatokat, ezzel korlátozva a NETs által kiváltott gyulladásos reakciókat és szövetkárosodást. Az SLE-ben szenvedő betegeknél gyakran megfigyelhető a DNáz I aktivitás csökkenése, ami hozzájárulhat a NETs felhalmozódásához és az autoimmun válasz kiváltásához.
Egyes bakteriális patogének azonban maguk is termelnek DNázokat, hogy elkerüljék a NETs csapdáit. Ezek a bakteriális DNázok virulencia faktorként működnek, lebontva a gazdaszervezet által termelt NETs-t, ezzel lehetővé téve a baktériumok elmenekülését és a fertőzés terjedését. Ez egyfajta „fegyverkezési verseny” a gazdaszervezet és a kórokozó között, ahol a DNázok mindkét oldalon kritikus szerepet játszanak. Például a Streptococcus pyogenes, a torokgyulladás és más súlyos fertőzések okozója, egy DNáz enzimet termel, amely segít neki elkerülni a NET-alapú immunválaszt.
Fejlődés és differenciáció
A DNázok szerepe nem korlátozódik a DNS javítására vagy lebontására. A fejlődésbiológiában és a sejtdifferenciációban is fontos feladataik vannak, különösen a kromatin szerkezetének dinamikus szabályozásában. A kromatin, a DNS és fehérjék komplex együttese, meghatározza a génexpressziót azáltal, hogy hozzáférhetővé vagy hozzáférhetetlenné teszi a géneket a transzkripciós faktorok számára. A kromatin szerkezetének finomhangolása elengedhetetlen a sejtek specializációjához és a szövetek kialakulásához.
Bizonyos DNázok, mint például az MNáz, vagy endogén nukleázok, hozzájárulnak a kromatin átrendeződéséhez a sejtdifferenciáció során. A specifikus DNS-régiók szelektív hasítása vagy az érzékeny DNS-szakaszok kialakítása befolyásolhatja a génszabályozást. Például a DNáz I érzékeny helyek (DNase I hypersensitive sites, DHS) olyan kromatin régiók, amelyek lazább szerkezetűek, és gyakran jelzik az aktív transzkripció helyeit, azaz ahol a gének aktívan kifejeződnek. Ezek a helyek könnyebben emészthetők DNáz I-gyel, ami azt sugallja, hogy endogén DNázok is részt vehetnek a kromatin dinamikájának finomhangolásában, a génexpresszió szabályozásában és a sejt sorsának meghatározásában. A fejlődés során a gének szelektív aktiválása és inaktiválása precíz kromatinmódosításokat igényel, amelyekben a DNázok indirekt vagy direkt módon is részt vehetnek.
Vírus replikáció és bakteriális virulencia
A vírusok és baktériumok gyakran manipulálják a gazdasejt DNázait, vagy saját DNázokat termelnek a túlélésük és replikációjuk érdekében. Ez egy folyamatos evolúciós harc a patogének és a gazdaszervezetek között.
Vírusok: Egyes vírusok, mint például a herpeszvírusok (pl. HSV-1), saját DNázokat kódolnak, amelyek segítik a vírusgenom replikációját, vagy lebontják a gazdasejt DNS-ét, hogy erőforrásokat szabadítsanak fel a vírus számára, és elkerüljék a gazdasejt antivirális válaszát. A vírus DNázok gyakran specifikusak a vírus replikációjához szükséges DNS-struktúrák felismerésére. Más esetekben a gazdasejt DNázai antivirális védelmet nyújtanak, lebontva a behatoló vírus DNS-ét, mielőtt az integrálódna a gazdasejt genomjába vagy replikálódna. A vírusoknak ezért ki kell alakítaniuk mechanizmusokat ezen gazda-DNázok elkerülésére vagy inaktiválására, például specifikus inhibitorok termelésével.
Baktériumok: Ahogy már említettük, számos patogén baktérium termel DNázokat virulencia faktorként. Ezek az enzimek lebontják a gazdaszervezet által termelt NETs-t, ezzel elkerülve az immunrendszer csapdáit és elősegítve a fertőzés terjedését. Ezenkívül egyes bakteriális DNázok hozzájárulhatnak a biofilm képződéséhez vagy lebontásához, ami szintén befolyásolja a baktériumok túlélését és patogenitását, különösen krónikus fertőzések esetén. A Streptococcus pneumoniae például egy DNáz B nevű enzimet termel, amely szerepet játszik a baktérium invazív képességében azáltal, hogy lebontja a gazdasejt DNS-ét, és így segíti a baktérium terjedését a szövetekben. A bakteriális DNázok célzott gátlása új antimikrobiális terápiák alapját képezheti.
A dezoxiribonukleázok alkalmazása a molekuláris biológiában és a biotechnológiában
A DNázok egyedi képessége, hogy specifikusan vagy nem-specifikusan hasítják a DNS-t, rendkívül értékes eszközökké tette őket a modern biológiai kutatásban és a biotechnológiai iparban. Számos laboratóriumi eljárás alapját képezik, a DNS tisztításától a génmanipulációig, és még terápiás célokra is alkalmazzák őket, forradalmasítva a biológiai kutatás és az orvosi diagnosztika számos területét.
DNS-mentesítés és RNS tisztítás
Az egyik leggyakoribb alkalmazás a DNS-szennyezés eltávolítása RNS mintákból. Az RNS izolálása során gyakran előfordul, hogy a minták genomiális DNS-t is tartalmaznak, ami zavarhatja az RNS-alapú downstream alkalmazásokat, mint például a reverz transzkripciós polimeráz láncreakciót (RT-PCR), a kvantitatív RT-PCR-t (RT-qPCR) vagy az RNS-szekvenálást. A genomiális DNS jelenléte hamis pozitív eredményekhez vagy pontatlan kvantifikációhoz vezethet, mivel a DNS-t is amplifikálhatják a PCR-primerek.
Az RNáz-mentes DNáz I kezelés hatékonyan lebontja a DNS-t anélkül, hogy károsítaná az RNS-t. Ez kritikus lépés a génexpressziós vizsgálatok pontosságának biztosításában, mivel elkerülhető a genomiális DNS amplifikációja. Az RNáz-mentesítés kulcsfontosságú, mert a legtöbb DNáz készítmény tartalmazhat RNS-t bontó enzimeket is, amelyek károsítanák az értékes RNS mintát. Hasonlóképpen, fehérje tisztítási protokollokban is alkalmazzák a DNázokat, hogy eltávolítsák a DNS-t a fehérjekészítményekből, elkerülve a viszkozitási problémákat és a potenciális szennyeződéseket, amelyek befolyásolhatják a fehérje funkcióját vagy a downstream elemzéseket.
Kromatin immunkoprecipitáció (ChIP) és nukleoszóma térképezés
A kromatin immunkoprecipitáció (ChIP) egy alapvető technika, amely lehetővé teszi a kutatók számára, hogy azonosítsák azokat a DNS-régiókat, amelyekhez specifikus fehérjék (pl. transzkripciós faktorok, hiszton módosító enzimek) kötődnek a sejtben. A ChIP eljárás egyik kulcsfontosságú lépése a kromatin emésztése, hogy a DNS-fehérje komplexek hozzáférhetővé váljanak az antitestek számára.
A mikrokokkális nukleáz (MNáz) gyakran használt enzim ebben a lépésben. Az MNáz szelektíven emészti a linkerer DNS-t, miközben a nukleoszómákhoz kötött DNS-t érintetlenül hagyja. Ezáltal lehetővé teszi a nukleoszómák izolálását és a nukleoszóma pozicionálásának, azaz a nukleoszómák genomon belüli elhelyezkedésének térképezését rendkívül nagy felbontásban. Az MNáz-seq technológia forradalmasította a kromatin dinamikájának és a génszabályozásnak a vizsgálatát, betekintést nyújtva abba, hogy a nukleoszómák hogyan befolyásolják a génexpressziót és a sejt sorsát. Az MNáz emésztés mértékének finomhangolásával a kutatók különböző kromatin régiók hozzáférhetőségét vizsgálhatják, ami kulcsfontosságú az epigenetikai szabályozás megértésében.
Környezeti DNS és metagenomika
A DNázok nem csak sejten belüli folyamatokban, hanem a környezeti minták elemzésében is szerepet kapnak. A környezeti DNS (eDNS), amely a talajban, vízben, levegőben vagy akár a hóban található, egyre inkább használatos az ökológiai monitoringban és a biodiverzitás felmérésében. Az eDNS lehetővé teszi a fajok jelenlétének kimutatását anélkül, hogy az élőlényeket közvetlenül meg kellene figyelni.
Azonban az eDNS minták gyakran tartalmaznak szabadon lebegő, fragmentált DNS-t, amelyet a természetes környezetben lévő DNázok már részben lebontottak. Ez a lebontás befolyásolhatja az eDNS mennyiségét és minőségét, ami kihívást jelenthet a metagenomikai vizsgálatok számára. A DNázok alkalmazhatók a nem-cél DNS lebontására a minták előkészítése során, vagy éppen az eDNS stabilitásának vizsgálatára a különböző környezeti tényezők hatására. A DNázok gátlása vagy semlegesítése kulcsfontosságú lehet az eDNS alapú vizsgálatok megbízhatóságának növelésében, különösen akkor, ha a mintákat hosszú ideig tárolják vagy szállítják. A DNáz aktivitás megértése segít optimalizálni az eDNS gyűjtési és elemzési protokolljait.
Diagnosztikai alkalmazások
A DNázok és aktivitásuk mérése diagnosztikai célokra is felhasználható, mivel számos betegség során a DNáz aktivitás szintje vagy a DNS lebontásának mintázata megváltozik.
- Cirkuláló, szabad DNS (cfDNS) detektálása: A vérplazmában található szabad DNS, a cfDNS, számos betegség, például rák, szepszis, trauma vagy autoimmun betegségek biomarkere lehet. A cfDNS-t a szervezet DNázai folyamatosan bontják. A DNáz aktivitás megváltozása vagy a cfDNS mennyiségének ingadozása információval szolgálhat a betegség állapotáról és progressziójáról. A cfDNS fragmentációs mintázata is diagnosztikus értékkel bírhat, mivel a különböző betegségek eltérő DNáz aktivitást indukálhatnak.
- Bakteriális fertőzések diagnosztikája: Egyes bakteriális patogének DNáz aktivitása kimutatható diagnosztikai tesztekkel. Például a Staphylococcus aureus DNáz aktivitása felhasználható a gyors azonosításra klinikai mintákban, segítve a megfelelő antibiotikumos kezelés kiválasztását. A DNáz-tesztek gyorsak és költséghatékonyak lehetnek, kiegészítve a hagyományos mikrobiológiai tenyésztési módszereket.
- DNáz aktivitás mérése autoimmun betegségekben: A DNáz aktivitás mérése a szérumban vagy más testnedvekben segíthet bizonyos autoimmun betegségek, például szisztémás lupus erythematosus (SLE) diagnosztizálásában, ahol a DNáz I aktivitás alacsonyabb lehet, ami a NETs felhalmozódásához vezethet. Az alacsony DNáz aktivitás prognosztikai markerként is szolgálhat az SLE-ben, jelezve a betegség súlyosságát és az esetleges fellángolás kockázatát.
- DNS integritás tesztek: A DNázok felhasználhatók a DNS integritásának vizsgálatára, például spermium mintákban. A spermium DNS fragmentációjának mértéke összefüggésbe hozható a férfi meddőséggel, és a DNázok segítségével végzett in vitro tesztek értékes információt nyújthatnak a diagnózishoz.
Terápiás lehetőségek: DNázok a gyógyításban
A dezoxiribonukleázok nem csupán diagnosztikai és kutatási eszközök, hanem ígéretes terápiás potenciállal is rendelkeznek. Különösen azok a betegségek, amelyekben a DNS felhalmozódása vagy a DNáz aktivitás zavara patogén szerepet játszik, képezik a terápiás beavatkozások célpontját, új utakat nyitva a gyógyításban.
Cisztás fibrózis (CF) kezelése: Dornase alfa (Pulmozyme)
Az egyik legsikeresebb és legismertebb terápiás alkalmazás a cisztás fibrózis (CF) kezelése. A CF egy örökletes betegség, amelyet a CFTR (cisztás fibrózis transzmembrán konduktancia regulátor) gén mutációi okoznak. Ez a mutáció a sűrű, tapadós nyák felhalmozódásával jár a tüdőben, ami krónikus gyulladáshoz és visszatérő bakteriális fertőzésekhez vezet. Ennek a nyáknak a viszkozitását jelentősen növeli a haldokló neutrofilekből származó, nagy mennyiségű extracelluláris DNS, valamint az aktin és más fehérjék, amelyek a gyulladásos folyamat során szabadulnak fel.
A dornase alfa (kereskedelmi nevén Pulmozyme) egy rekombináns humán DNáz I, amelyet inhalációs formában alkalmaznak a CF-es betegeknél. A dornase alfa lebontja a sűrű nyákban lévő DNS-t, ezáltal csökkenti annak viszkozitását és megkönnyíti a légutakból való eltávolítását. Ez javítja a tüdőfunkciót, csökkenti a fertőzések gyakoriságát és javítja a betegek életminőségét. A dornase alfa rendszeres alkalmazása jelentősen hozzájárult a CF-es betegek várható élettartamának növeléséhez és a tünetek enyhítéséhez. Ez a terápia paradigmaváltó volt a CF kezelésében, demonstrálva a DNázok közvetlen terápiás potenciálját egy komplex genetikai betegségben.
Autoimmun betegségek és a NETs modulációja
Ahogy korábban említettük, a neutrofil extracelluláris csapdák (NETs) túlzott vagy nem megfelelő lebontása hozzájárulhat autoimmun betegségek, mint például a szisztémás lupus erythematosus (SLE) patogeneziséhez. SLE-ben a betegek gyakran alacsonyabb szérum DNáz I aktivitással rendelkeznek, ami a NETs felhalmozódásához és az autoantitestek képződéséhez vezethet a NETs komponensei (DNS, hisztonok) ellen. Ez a folyamat krónikus gyulladást és szövetkárosodást okoz.
Ennek okán a DNázok, különösen a rekombináns DNáz I, potenciális terápiás célpontot jelentenek ezen betegségek kezelésében. A DNáz I alkalmazásával csökkenthető a keringő NETs mennyisége, ezáltal mérsékelhető a gyulladás és az autoimmun válasz. Jelenleg folynak kutatások a DNáz alapú terápiák hatékonyságának és biztonságosságának felmérésére autoimmun kórképekben, beleértve a klinikai vizsgálatokat is. A kihívást a DNázok specifikus célba juttatása és az esetleges mellékhatások minimalizálása jelenti, de az alapkoncepció ígéretes.
„A DNázok nem csupán molekuláris ollók, hanem precíziós eszközök a betegségek elleni küzdelemben, a cisztás fibrózistól az autoimmun rendellenességekig, új reményt adva a betegeknek.”
Rákterápia és tumormikrokörnyezet
A rákterápiában is felmerült a DNázok alkalmazásának lehetősége. A tumormikrokörnyezet gyakran gazdag szabadon lebegő DNS-ben, amelyet tumorsejtek, haldokló immunsejtek vagy bakteriális komponensek bocsátanak ki. Ez a DNS hozzájárulhat a gyulladáshoz, az immunválasz elnyomásához és a tumor progressziójához, mivel aktiválhatja a cGAS-STING útvonalat, ami krónikus gyulladáshoz és immunoszuppresszióhoz vezethet.
A DNázok alkalmazásával, például a tumorba juttatott enzimekkel, lebontatható ez a szabad DNS, potenciálisan csökkentve a tumormikrokörnyezet immunoszuppresszív jellegét és javítva az immunterápiák hatékonyságát. Ezenkívül, egyes rákelhárító stratégiák a tumorsejtek apoptózisának indukálására fókuszálnak, ahol a DNázok, mint a CAD, kulcsszerepet játszanak a DNS fragmentációjában. A DNázok aktivitásának modulálása tehát új utakat nyithat meg a rákkezelésben, akár önálló terápiaként, akár más daganatellenes szerekkel kombinálva.
Antimikrobiális stratégiák
A bakteriális biofilm-képződés, amely számos krónikus fertőzésben (pl. katéterrel összefüggő fertőzések, cisztás fibrózisban a tüdőfertőzések, implantátumok fertőzései) kulcsszerepet játszik, gyakran jár együtt extracelluláris DNS (eDNS) felhalmozódásával, amely a biofilm mátrixának egyik alapvető komponense. Az eDNS stabilizálja a biofilm szerkezetét, elősegíti a baktériumok adhézióját és hozzájárul az antibiotikum rezisztenciához, mivel gátolja az antibiotikumok behatolását a biofilmbe.
A DNázok alkalmazása, különösen az eDNS-t hatékonyan bontó enzimek, ígéretes stratégiát jelenthet a biofilm lebontására és az antimikrobiális szerek hatékonyságának növelésére. A biofilm lebontása érzékenyebbé teheti a baktériumokat az antibiotikumokkal szemben, és segíthet a krónikus fertőzések felszámolásában. Kombinált terápiák, ahol a DNázokat antibiotikumokkal együtt alkalmazzák, ígéretes eredményeket mutattak in vitro és in vivo modellekben egyaránt, megnyitva az utat új, hatékonyabb antimikrobiális kezelések előtt.
A DNáz aktivitás szabályozása és modulációja
A DNázok létfontosságú szerepe miatt aktivitásuk szigorú szabályozás alatt áll a sejtekben. Ennek a szabályozásnak a megértése kulcsfontosságú a biológiai folyamatok tisztázásához és új terápiás beavatkozások kidolgozásához, hiszen a nem megfelelő DNáz aktivitás súlyos patológiás állapotokhoz vezethet.
Endogén inhibitorok és aktivátorok
A DNázok aktivitását gyakran endogén fehérjék vagy ionok modulálják. Például a már említett ICAD (inhibitor of CAD) egy specifikus fehérje, amely gátolja a CAD aktivitását a nem-apoptotikus sejtekben, megakadályozva a DNS idő előtti lebontását. Csak apoptotikus stimulus hatására, kaszpáz-3 általi hasítás után szabadul fel az ICAD-ról a CAD, és kezdi meg működését a sejtmagban. Ez a precíz szabályozás biztosítja, hogy a DNS fragmentáció csak akkor történjen meg, amikor arra szükség van, elkerülve a nem kívánt genetikai károsodást.
Az ionok, mint a Mg2+ és Ca2+, szintén kritikus szerepet játszanak számos DNáz aktivitásában. A DNáz I például magnézium-függő, és a kalciumionok jelenléte módosíthatja a hasítási mintázatát, befolyásolva, hogy az enzim egyszálú töréseket (nicks) vagy kétszálú töréseket (double-strand breaks) generál-e. A sejten belüli ionkoncentrációk változása így közvetlenül befolyásolhatja a DNáz aktivitást, ami egy gyors és hatékony szabályozási mechanizmust jelent a sejt számára. Más DNázok, mint például a DNáz II, fémion-függetlenek, vagy más fémionokat (pl. Zn2+) igényelnek, ami tovább növeli a szabályozási mechanizmusok diverzitását.
Sejtes lokalizáció és kompartmentalizáció
A DNázok lokalizációja a sejtben szintén fontos szabályozási mechanizmus. Sok DNáz a lizoszómákban (pl. DNáz II) vagy a mitokondriumokban (pl. Endonukleáz G) található meg, amelyek savas pH-jú környezetet biztosítanak az optimális működésükhöz. Ez a kompartmentalizáció biztosítja, hogy a DNázok csak akkor és ott fejtsék ki hatásukat, ahol arra szükség van, megelőzve a normális, funkcionális DNS károsodását. Az apoptózis során ezek az enzimek felszabadulhatnak a citoplazmába, majd a sejtmagba, ahol hozzájárulnak a DNS lebontásához.
A sejtmagban található DNázok, mint a CAD, szintén szigorúan szabályozottak, és csak akkor aktiválódnak, ha a sejt egy programozott sejthalál útvonalra lép. Ez a térbeli és időbeli szabályozás alapvető a sejt integritásának fenntartásában, és biztosítja, hogy a DNS lebontása kontrollált módon történjen, elkerülve a káros következményeket. A lokalizáció megváltozása, például a nukleáris-citoplazmatikus transzport útján, kulcsszerepet játszik a DNázok aktiválásában vagy inaktiválásában.
Transzkripciós és poszt-transzkripciós szabályozás
A DNázok expressziója, azaz termelődése, is szabályozott. Génjeik transzkripcióját számos faktor befolyásolhatja, válaszul különböző celluláris stresszre (pl. oxidatív stressz, DNS-károsodás), hormonális jelekre vagy fejlődési programokra. Ez a reguláció biztosítja, hogy a sejt a megfelelő mennyiségű és típusú DNáz enzimet termelje a változó igényeknek megfelelően.
Ezenkívül a poszt-transzkripciós módosítások, mint a foszforiláció, acetiláció vagy proteolitikus hasítás, szintén befolyásolhatják az enzimek stabilitását, aktivitását és lokalizációját. Például a DNázok foszforilációja aktiválhatja vagy inaktiválhatja őket, vagy megváltoztathatja a fehérje-fehérje interakciójukat, ami kihat a működésükre. A DNáz I expressziója változhat a szövetekben és a fejlődés különböző szakaszaiban, jelezve, hogy a sejtek aktívan szabályozzák a DNS-lebontó kapacitásukat a specifikus fiziológiai igényeknek megfelelően. A DNázok szabályozásának bonyolult hálózata rávilágít arra, hogy milyen finoman hangoltak a sejtes folyamatok a genetikai anyag védelme és manipulálása terén, biztosítva a biológiai rendszerek stabilitását és adaptációs képességét.
Jövőbeli perspektívák és kutatási irányok
A dezoxiribonukleázok kutatása továbbra is dinamikusan fejlődik, új felfedezésekkel és innovatív alkalmazásokkal gazdagítva a biológia és az orvostudomány területét. A genomika, proteomika és a szintetikus biológia fejlődése új lehetőségeket nyit meg ezen enzimek mélyebb megértésére és manipulálására. A jövőbeli kutatások valószínűleg a DNázok molekuláris mechanizmusainak még mélyebb megértésére, a szabályozási hálózatok feltárására és új terápiás stratégiák kidolgozására fókuszálnak.
Új terápiás célpontok és biomolekuláris beavatkozások
Az autoimmun betegségek, a rák és a fertőző betegségek patogenezisében a DNázok által játszott szerep feltárása új terápiás célpontokat kínál. A DNáz aktivitás modulálása – akár aktiválással, akár gátlással – lehetőséget biztosíthat a betegségek progressziójának befolyásolására.
Például a DNáz inhibitorok kifejlesztése, amelyek szelektíven blokkolják a patogén baktériumok által termelt DNázokat, új antimikrobiális szereket eredményezhet, amelyek kevésbé hajlamosak rezisztencia kialakítására, mint a hagyományos antibiotikumok. Ezzel szemben a DNáz aktivitás fokozása, például a rekombináns enzimek célzott bejuttatásával, ígéretes lehet olyan állapotokban, ahol a DNS felhalmozódása káros, mint például a cisztás fibrózisban vagy bizonyos autoimmun kórképekben. A génterápiás megközelítések, amelyek a DNázok expresszióját módosítják, szintén ígéretes utat jelenthetnek a genetikai rendellenességek kezelésében. A nanotechnológia felhasználása a DNázok célzott szállítására is egyre inkább előtérbe kerül.
Fejlettebb diagnosztikai módszerek
A DNáz aktivitás és a szabad DNS mennyiségének pontosabb mérése új generációs diagnosztikai eszközökhöz vezethet. A nagy érzékenységű, specifikus DNáz aktivitás-tesztek segíthetnek a betegségek korai felismerésében, a terápia monitorozásában és a prognózis felállításában, még mielőtt a tünetek súlyossá válnának.
A cirkuláló, szabad DNS (cfDNS) elemzése, beleértve annak fragmentációs mintázatát, amely a DNáz aktivitás tükre, egyre inkább előtérbe kerül a „folyékony biopsziában” a rákdiagnosztikában és a transzplantációs medicina területén. Az új technológiák, mint a digitális PCR és a következő generációs szekvenálás, lehetővé teszik a cfDNS rendkívül pontos elemzését, és a DNázok ezen folyamatokban betöltött szerepének mélyebb megértését. A cfDNS profilozása révén a kutatók remélik, hogy non-invazív módon tudnak információt szerezni a tumorok genetikai és epigenetikai jellemzőiről, valamint a transzplantált szervek állapotáról.
A DNázok szerepe a genomszerkesztésben és szintetikus biológiában
Bár a genomszerkesztésben elsősorban a restrikciós endonukleázokhoz hasonló, de még specifikusabb nukleázok (pl. CRISPR/Cas rendszerek, TALEN-ek, cinkujj nukleázok) kerültek előtérbe, a DNázok alapvető működési elvei, azaz a DNS precíz hasítása, inspirációt nyújtanak. A jövőben elképzelhető, hogy a DNázok új, módosított változatait fejlesztik ki, amelyek még specifikusabb célzással és kontrollal képesek hasítani a DNS-t, ezzel bővítve a genomszerkesztés eszköztárát.
A szintetikus biológiában a DNázok felhasználhatók a mesterséges DNS-molekulák és genomiális rendszerek tervezésére és építésére. Az enzimek precíz irányításával a kutatók új funkciókat hozhatnak létre, vagy meglévő biológiai rendszereket optimalizálhatnak. A DNázok, mint a molekuláris biológia alappillérei, továbbra is kulcsszerepet fognak játszani a genetikai kutatás, az orvostudomány és a biotechnológia jövőjének alakításában. A róluk szerzett tudás folyamatosan bővül, és egyre inkább lehetővé teszi számunkra, hogy manipuláljuk és kihasználjuk ezeket az enzimeket az emberi egészség és a tudományos fejlődés szolgálatában. A jövő tartogat még sok izgalmas felfedezést ezen lenyűgöző molekuláris gépezetek működésével és alkalmazásával kapcsolatban, amelyek mélyebb betekintést engednek az élet titkaiba.
